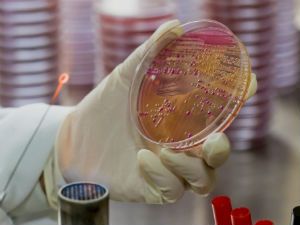
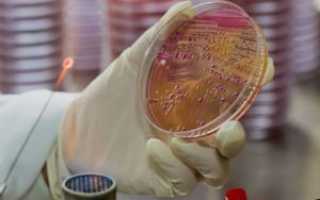

Если человек здоров, в моче не должно содержаться никаких бактерий. Если в ходе анализа была обнаружена кишечная палочка в моче, это свидетельствует о развитии патологического процесса. При выявлении в урине эшерихии коли требуется незамедлительно приступить к лечению, в противном случае существует вероятность развития воспалительного процесса в органах мочеполовой системы.
Также микроорганизмы этого типа могут спровоцировать развитие пиелонефрита, цистита и других опасных болезней. Прежде чем назначать схему лечения, необходимо провести полноценную диагностику и выявить, что именно стало причиной такого отклонения.
Показатели нормы
Обнаружив в бланке с результатами присутствие в моче бактерий типа escherichia coli, многие мужчины и женщины начинают паниковать. Но специалисты предупреждают, что присутствие в урине этого микроорганизма не всегда является поводом для беспокойства.
Если биохимический анализ показал, что кишечная палочка в урине не превышает 10 в 3-й степени или 10 в 4-й степени, это не является отклонением от нормы. При таком результате ставится отрицательная реакция. Стоит учитывать, что нормативы одинаковы для представителей обеих полов и всех возрастных групп.
Если анализ покажет, что количество бактерий превышает 10 единиц в 5-1 степени, это признак нарушения микрофлоры урины. Также подобная реакция может указывать на наличие урологического заболевания. Расшифровка анализа всегда проводится урологом, который выписал направление на обследование.
Причины появления
Бактерии типа эшерихия коли в моче у женщин и мужчин могут присутствовать по самым разным причинам. Но в не зависимости от того, что именно служит первоисточником патологии, вывести микроорганизмы очень сложно. Примерно в 25% случаев их присутствие является безопасным для здоровья, но чаще обнаружение палочки говорит об опасных патологических процессах.
Основными причинами возникновения в органах мочеполовой системы болезнетворных бактерий этого типа являются:
- воспаление стенок мочевого пузыря (почек, выделительных каналов), сопровождающееся множественными осложнениями. Присутствие кишечной палочки в этом случае обусловлено тем, что воспалительный процесс ослабевает местный иммунитет и организм не может справиться с активностью кишечной палочки;
- несоблюдение правил личной гигиены. Чаще всего отсутствие должного ухода обнаруживается у мужчин, которые отказываются от ежедневного приема душа;
- беспорядочные сексуальные связи;
- неправильный сбор биоматериала для анализа и использование нестерильной емкости. Чтобы результаты анализа были достоверными, сбор мочи рекомендуется осуществлять в специальный пластиковый контейнер, продающийся в аптеке;
- у детей этот инфекционный возбудитель часто обнаруживается из-за дисбактериоза кишечника. При этом заболевании в организме начинают преобладать патогенные микроорганизмы;
- анальный секс без презервативов.
Также вероятность появления в урине кишечной палочки повышается у беременных женщин (мазок показывает нарушение микрофлоры более чем в 30% случаев). Такая реакция связана с ослаблением иммунитета и повышенными нагрузками на организм. Подробнее о появлении кишечной палочки в моче у беременных можно прочитать в этой статье.
Симптоматика
Если органы мочевыделительной системы поражены кишечной палочкой, признаки патологии не заставят себя долго ждать. Симптомы недуга всегда проявляются остро и при отсутствии своевременного лечения могут спровоцировать развитие хронических заболеваний. Именно поэтому при появлении сомнительных признаков требуется незамедлительно обратиться к врачу.
Чаще присутствие кишечной палочки в моче у ребенка и взрослого сопровождается такой симптоматикой:
- появление резкой и жгучей боли во время опорожнения мочевого пузыря;
- слизистая выделительного канала приобретает отечный вид. Также может наблюдаться незначительное покраснение эпителиальной поверхности;
- частые позывы к мочеиспусканию. Подобная симптоматика свидетельствует о том, что микроорганизм проник в мочевой пузырь;
- выводимая урина приобретает более темный оттенок и становится концентрированной. В некоторых случаях может измениться и запах мочи. Этот признак является опасным и указывает на развитие урологических заболеваний инфекционной природы;
- присутствие в моче гнойных примесей и небольших сгустков крови;
- общая ослабленность организма;
- дискомфорт и незначительная болезненность в области почек;
- озноб и повышение температуры тела.
В редчайших случаях патология может повлечь за собой возникновение сыпи на коже половых органов. Такая реакция организма говорит о сильном ослаблении иммунитета и требует профессиональной помощи.
Прежде чем назначать схему лечения и прописать пациенту медикаменты, врач должен убедиться, действительно ли в моче присутствует кишечная палочка коли. Как показывает медицинская практика, примерно в 20% случаев результат анализа оказывается ложноположительным.
Такая реакция может быть следствием следующих нарушений: несоблюдение правил гигиены перед сбором мочи (если не провести гигиену половых органов, патогенные микроорганизмы могут попасть в мочу из биологических выделений), сбор биоматериала в нестерильную емкость, прием некоторых медикаментов накануне.
Сложность бактериологического исследования заключается в том, что медику необходимо отличить бактерии, присущие естественной микрофлоре, от патогенных клеток. Сделать это можно, только определив скорость образования колоний. Наиболее достоверный результат будет известен при проведении биохимического анализ или морфологического исследования.
Если в посеве мочи нашли следы кишечной палочки, назначается повторное исследование. В качестве дополнительных мер лечащий врач может выдать пациенту направление на общий анализ крови и каловых масс. Анализы помогут оценить общую клиническую картину и выявить, почему в урине появился патогенный микроорганизм.
Особенности у ребенка
Довольно часто присутствие бактерий типа эшерихия коли обнаруживается в анализе мочи у детей и грудничков. Часто причина положительной реакции кроется в неправильном сборе биоматериала. Чтобы избежать ложных показаний, врачи советуют родителям собирать урину у детей маленького возраста и грудничков в специальные мочеприемники, которые продаются в аптеках.
Если анализ показал положительный результат, через несколько дней назначается повторное исследование. Если оно покажет аналогичную реакцию, врач назначает дополнительную диагностику, что поможет выявить причину возникновения недуга. Приступать к лечению недуга можно будет только после постановки правильного диагноза.
Методы лечения
Заранее сказать, какой способ лечения кишечной палочки в моче будет назначен, невозможно, поскольку терапия носит индивидуальный характер и зависит от первоисточника заболевания. Чаще всего пациентам назначают прием сразу нескольких медикаментов разных фармкатегорий, действие которых направлено на очищение тканей мочеполовой системы от патогенных микроорганизмов.
При этом необходимо учитывать, что эшерихия отличается большим количеством штаммов, поэтому пациенту обязательно придется принимать антибактериальные средства. Антибиотики также подбираются индивидуально для каждого пациента с учетом типа бактерий и их восприимчивости к активным компонентам препарата.
Чаще всего урологические патологии, вызванные кишечной палочкой, лечатся при помощи следующих препаратов:
- антибиотики. Избавиться от микроорганизмов типа Эшерихия коли помогают практически все антибиотики, относящиеся к группе аминогликозидов (Нетилмицин, Неомицин, Тобрамицин). Дозировка препарата и длительность приема подбираются исключительно лечащим врачом. Пациенту может быть назначен прием антибиотиков в таблетированной форме либо внутримышечное введение препарата;
- средства от дисбактериоза. Помогают восстановить баланс полезных и вредоносных микроорганизмов и активизируют работу иммунной системы. Чтобы восстановить организм после антибактериальной терапии, чаще назначают Линекс, Дюфалак, Нормазе;
- противовоспалительные спазмолитические средства;
- также пациентам назначается ежедневное потребление кисломолочных продуктов. Молоко, сметана, кефир и творог способствуют укреплению иммунитета и помогают восстановить организм после антибактериальной терапии.
Вне зависимости от того, что вызвало присутствие кишечной палочки в моче, основу лечебного курса составляют антибактериальные препараты. В большинстве случаев продолжительность терапии варьируется от 10 до 15 суток. Длительность лечения зависит от восприимчивости бактериями активных компонентов препарата, а также от динамики выздоровления.
Если препарат будет подобран правильно, улучшения будут заметны уже через 3-4 дня – симптоматика заболевания станет менее выраженной. При этом пациентам необходимо помнить, что при первых симптомах выздоровления бросать лечение нельзя. При прерывании терапии часть патогенных микроорганизмов останется на слизистых оболочках органов мочеполовой системы, в результате чего через пару недель может произойти рецидив.
Лечить кишечную палочку в моче можно и при помощи нетрадиционной терапии. Но необходимо понимать: народные средства можно использовать только в качестве вспомогательных. Если весь упор будет сделан на них, смысла от терапии не будет.
Несмотря на то, что представители официальной медицины не приветствуют такой способ лечения, применение народных рецептов против разных недугов широко используется разными слоями населения. Самыми эффективными и действенными считаются следующие способы борьбы с недугом.
Это минеральное вещество является мощным активатор иммунной системы. Мумие принимают на голодный желудок перед завтраком (по 0,5 гр.). Курс лечения – 30 суток. По истечении месяца нужно сделать 5-дневный перерыв и в случае необходимости пройти повторный курс лечения (в большинстве случаев он не требуется). Представительницам прекрасного пола также можно делать спринцевания при помощи раствора на основе этого компонента. Для его приготовления нужно развести 1 гр. мумие в стакане теплой воды.
В продукте содержится множество полезных лактобактерий, подавляющих распространение кишечной палочки и восстанавливающих микрофлору кишечника. Сыворотку рекомендуется принимать утром, днем и вечером (по стакану) за 15 минут до еды. Продолжительность курса лечения составляет 15 суток.
Для приготовления целебного напитка требуется выкопать 300 гр. земляной груши и как следует вымыть корнеплоды. Далее их заливают литром воды и ставят на плиту. Корнеплоды необходимо кипятить на протяжении 20-30 минут. После готовности полученный отвар остужают. Его принимают по 100 гр. 3 раза в день (перед приемом пищи). Корнеплоды также можно не выкидывать, а употребить в пищу.
Это целебное растение можно использовать для приготовления чая, обладающего противовоспалительным и антибактериальным действием. Для его приготовления нужно залить столовую ложку сухого растения стаканом кипятка, накрыть крышкой и дать настояться 30 минут. Напиток рекомендуется выпивать за раз, оптимальная суточная доза – 1 стакан. Такой чай пьется без добавления сахара и только на голодный желудок. Принимать его рекомендуется на протяжении 10-12 дней.
Профилактические меры
Чтобы свести к минимуму риск появления в моче кишечной палочки, необходимо знать, откуда берется этот микроорганизм, и знать пути его передачи. Врачи советуют придерживаться таких рекомендаций:
- необходимо соблюдать правила личной гигиены и следить за чистотой тела;
- категорически запрещено потреблять в пищу плохо вымытые продукты;
- запрещено вести беспорядочную половую жизнь и экспериментировать с нетрадиционной интимной жизнью.
Чтобы оградить себя от такого недуга, нужно вести здоровый образ жизни, правильно питаться и заниматься укреплением иммунной системы.
Заключение
Несмотря на то, что кишечная палочка в моче хорошо поддается лечению, ее присутствие может вызвать определенные проблемы со здоровьем, вплоть до развития хронических заболеваний. Именно поэтому при возникновении первых сомнительных признаков требуется незамедлительно обратиться к врачу и пройти полноценное обследование.
*Импакт фактор за 2018 г. по данным РИНЦ
Журнал входит в Перечень рецензируемых научных изданий ВАК.
Читайте в новом номере
Инфекции мочевыводящих путей (ИМП) относятся к числу наиболее распространенных инфекционных заболеваний. Как причина обращения пациентов в амбулаторные лечебные учреждения ИМП занимают в настоящее время 2–е место после инфекций респираторного тракта. В США ИМП являются причиной более 7 млн обращений к врачу в год, из которых более 2 млн – по поводу острого цистита. Распространенность ИМП в Российской Федерации составляет около 1000 случаев на 100 тыс. населения и имеет тенденцию к росту [1–3].
Кишечная палочка в моче появляется, когда показатель концентрации ее в организме отклоняется от нормы в большую сторону, то микроорганизм заселяет ближайшие органы. Одним из мест, наиболее частого поражения выступает мочеиспускательный канал, т.к. расположен он ближе всего к очагу образования патогенной микрофлоры. В норме среда их обитания – кишечник, а показатель у взрослого человека и новорожденного в диапазоне 106-108 КОЕ/г.
Содержание статьи
Что собой представляет кишечная палочка
Сама по себе кишечная палочка не вредна – она может быть патогенной лишь в том случае, если ее значение в рамках анализов существенно превышает норму. Дело в том, что энтеробактерии изначально приносят организму и ЖКТ пользу. Подпитка клеток происходит за счет температуры тела человек, необходимой им влажности, кислорода и других условий жизнедеятельности. Они же, в свою очередь, обеспечивают организм жирными кислотами, витаминами К и В. Участвуют в расщеплении белка, метаболизируют билирубин, холестерин и желчные кислоты. Кроме того, они уничтожают патогенные бактерии и не дают возможности распространиться им в собственной среде обитания.

Основные факторы, влияющие на отклонения от нормы:
- Вирусные заболевания в течение продолжительного времени или частые рецидивы.
- Повышенные нагрузки физической и эмоциональной (стрессы).
- Нарушение функционирования внутренних органов (особенно актуально для пожилых людей).
- Курение, алкоголь и наркотические вещества также способны провоцировать размножение условно-патогенных бактерий и расширение среды обитания.
Причины появления в урине
Моча здорового человека не должна содержать бактерий, поэтому кишечная палочка в норме там присутствовать не должна. Исключением являются случаи, когда органы системы мочеиспускания поражены какими-либо патологическими процессами. Обнаружить данный факт можно совершенно случайно, при сдаче в рамках планового профосмотра общего анализа мочи, или в момент диспансеризации по поводу другой болезни, но все же бессимптомная форма встречается намного реже. Куда как чаще процесс сопровождается жалобами со стороны пациента, поэтому он отправляется лечащим врачом в лабораторию для проведения исследований с определенными подозрениями.
Пробы берутся для проведения:
Какие заболевания вызывает
Причинами попадания кишечной палочки в мочу могут быть заболевания половой и мочевой системы и размножение патогенных и условно-патогенных микроорганизмов. Способствующими факторами можно назвать тесное белье, несоблюдение правил личной гигиены и анальные половые акты. Следствие – воспаление мочевого пузыря, почек, уретры. Среди заболеваний наиболее распространены пиелонефриты и циститы.
Пиелонефрит относится к воспалительным заболеваниям, в результате которых происходит перемещение инфекции (кишечной палочки) от уретры к почкам, заполняя лоханки и заражая почки. Восхождение воспалительного процесса наблюдается у женщин. У мужчин в силу особенностей анатомического строения мочеполовой системы такого рода осложнения не выявлены.
Особый риск бактерия представляет для беременных женщин, и вне зависимости от сложности заболевания, чтобы предотвратить воспалительный процесс, таким пациенткам назначают курс антибиотиков.
Расшифровка анализов
Как уже говорилось, есть 2 варианта проведения исследования – это общий анализ и бакпосев. В первом случае отображается наличие бактерий – выявлено / не выявлено. И только второй, после лабораторных исследований и выстраивания колонии в благоприятных условиях, может отображать их вид и чувствительность к антибиотикам.
Причины бактериурии
Если рассматривать вопрос о причинах возникновения бактерий любого типа в урине и мочевыводящем канале человека, то следует выделить два пути их образования.
- Истинная бактериурия. Размножение происходит непосредственно в урине, провоцируя воспалительные процессы и перемещение болезнетворных клеток к другим органам.
- Ложная бактериурия. Появление микроорганизмов связано с заболеванием смежных мочеполовой системе органов, т.е. в данном случае кишечника.
Бактериурия – это симптом, а не само заболевание, и помимо сдачи анализов, потребуется пройти обследование других органов. Реже диагностируют патологии, связанные с аденомой, сахарным диабетом и простатитом, уретритом и бактериальным сепсисом.
Чаще других выявляют уретрит, цистит и пиелонефрит. Симптомами следует считать:
- Нарушение мочеиспускания, сопровождающиеся болью или жжением – дизурия.
- Болезненное состояние поясницы и живота внизу.
- Недержание.
- Неприятный запах урины, и виднеющиеся в ней примеси гноя;
- Гиперемия уретры.
О чём свидетельствует бессимптомная бактериурия
Бессимптомная бактериурия свидетельствуют о заболевании при отсутствии его характерных признаков. Анализы у пациентов говорят о наличии колоний микроорганизмов в уретре, в сочетании с повышенной концентрацией лейкоцитов, но человек при этом не испытывает дискомфорт. Такие обстоятельства лишь осложняют картину, т.к. несвоевременная диагностика может повлечь за собой инфицирование и заболевание других органов, включая брюшную полость и половую систему.
Причинами отсутствия симптомов может быть как индивидуальная особенность отдельно взятого пациента, так и устойчивость, связанная с большим количеством рецидивов заболевания.
Когда результаты могут быть неточными
- В случае несоблюдения правил забора анализов или личной гигиены. Попадание в мочу выделений из половых органов.
- Забор мочи в нестерильную тару.
- Влияние могут оказывать лекарственные препараты и проводимые диагностические исследования накануне.
Обследование при появлении кишечной палочки в моче
Единственным способом обследования, выявляющий тип бактерии, является бактериологическое исследование. Сложностью является определение в пробе эшерехий, присущих естественной микрофлоре, патогенных клеток. Определить колонии можно по скорости их образования, но наиболее точные результаты будут лишь при биохимическом и морфологическом исследовании.

Дополнительно делают забор пробы слизистых, а также рвотных и каловых масс, крови, гноя, мазков, в зависимости от предварительного диагноза и на усмотрение лечащего доктора. Очевидно, что результаты могут быть скрытые, ложные или демонстрировать объективную картину. Важным является своевременное обращение к специалисту при первых признаках заболевания, во избежание развития патологий и заражения бактерией ближайших органов.
Лечение
При появлении кишечной палочки рекомендуется лечение у врача. Терапия при обнаружении возбудителя инфекции мочевыводящей и мочеобразующей системы проводится в комплексе физиотерапевтическими процедурами. Назначаются препараты следующих групп:
- антибиотики;
- нестероидные противовоспалительные средства;
- травяные сборы.
При образовании абсцесса почечной лоханки проводится оперативное лечение.
Профилактика инфекции мочевыделительной системы
Чтобы избежать появления кишечной палочки в моче, рекомендуется избегать переохлаждений, соблюдать меры гигиены, при нарушении процесса мочеиспускания – обращаться к врачу.
Читайте также: